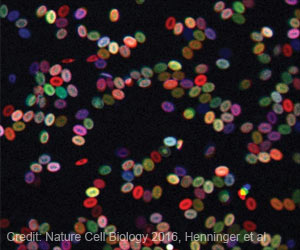
Cell Mechanism Regulating Protein Synthesis in Stress Conditions Identified

Non-invasive tRNA measurement in the blood provides accurate and affordable diagnosis and prognosis.

TOP INSIGHT
Non-invasive tRNA measurement in the blood provides accurate and affordable diagnosis and prognosis.
Cells naturally modify RNA molecules to enhance their stability, structure, and function. When this modification process goes wrong, it can have important consequences for human health and disease.
In the case of tRNA, incorrect or missing modifications produce faulty or incomplete proteins, with the dysregulation of tRNA modifications being linked to various human diseases, including neurodegenerative diseases, metabolic diseases, and cancer.
Non-Invasive tRNA Blood Measurement
tRNAs are “information-rich” molecules with huge potential for the diagnosis and prognosis of diseases, but so far haven’t been exploited for such purpose due to the lack of methods that can capture this information in a quantitative and cost-efficient manner.For example, some types of cancers are difficult to diagnose because their symptoms are non-specific and can be confused with other conditions. At the same time, certain tRNA modification profiles are only known to exist in specific cancer types and can serve as highly-specific biomarkers.
Furthermore, the type of tRNA modifications can change depending on the state of the disease, providing valuable information about the prognosis of the condition.
Researchers at the Centre for Genomic Regulation (CRG) in Barcelona have addressed this challenge by developing a new method that can measure both the abundance and modification of tRNA molecules in a single step. The method is called Nano-tRNAseq and is first described today in the journal Nature Biotechnology.
Nano-tRNAseq is based on nanopore sequencing, a technology that can directly sequence individual RNA molecules by passing them through a small pore.
Each of the nucleotides that compose an RNA molecule has a slightly different size and shape, with a corresponding change in the electrical current that occurs as each nucleotide passes through the pore.
Computer programs detect changes in the current to identify the sequence of the RNA molecules, including any modifications. As a proof of concept, the researchers used Nano-tRNAseq to accurately measure tRNA abundances and modifications in samples taken from yeast cells exposed to different environmental conditions.
Cutting-Edge Technology: tRNA Measurement
The method has significant advantages over conventional techniques. “For the first time, we can study both tRNA abundance and tRNA modification profiles simultaneously. As a bonus, the method is rapid, cost-effective, high-throughput, and has a single-molecule resolution. Previously, we relied on two separate methods that, together, are less informative, and it would take weeks and cost thousands of euros to obtain results. Nano-tRNAseq is a fraction of the cost, and we can have results within a couple of days, and in the near future, within a few hours” says Morghan Lucas, PhD candidate at the Centre for Genomic Regulation and first author of the study.The rapid data analysis enabled by the method is critical for clinical decision-making. Another advantage is that the nanopore sequencing machines required for the technique are small, lightweight, and can be powered by a laptop or portable battery, making them easy to transport to remote locations and enabling use in the field or the clinic.
The researchers note there are still some limitations to the new method, such as the inability to predict which tRNA modification is dysregulated in a given sample unless the precise modifications found in that tRNA have been previously identified using other experimental methods.
“While tRNA modification profiles of lower eukaryotic species, such as yeast, are well characterized, this is not the case for humans. By using Nano-tRNAseq in parallel with other methods, we can describe the modification profiles of the complete set of human tRNAs and, in the future, use Nano-tRNAseq to identify which changes in tRNAs are associated with a given human disease,” adds Morghan Lucas.
The method was developed by Dr. Eva Novoa’s research group at the Centre for Genomic Regulation (CRG). Dr. Novoa plans on using the technology to further her research efforts funded by the Spanish Association Against Cancer (AECC).
“tRNA molecules can be cleaved into small but stable RNA fragments which circulate in blood plasma. These molecules are typically altered in cancer patients and are hugely information-rich for diagnostic and prognostic purposes. Nano-tRNAseq is a proof-of-concept technology that paves the way for the development of a simple, cost-effective, and highly-precise method that can quantify these molecules in a non-invasive manner. Our aim is to further develop this technology and combine it with artificial intelligence tools to determine the malignancy of a biological sample in less than 3 hours, and at a cost of no more than 50 euros per sample” says Dr. Eva Novoa, senior author of the study and researcher at the Centre for Genomic Regulation.
Source-Eurekalert
MEDINDIA

Email







